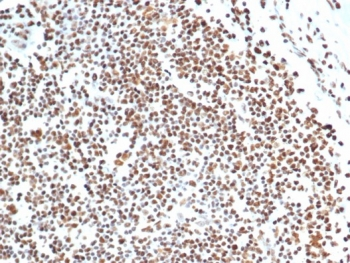
XRCC5 Antibody
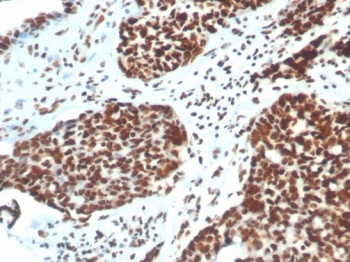
XRCC5 Antibody

You have no items in your shopping cart.
Human Transferrin protein
SKU: orb3148125
Description
Images & Validation
−
Key Properties
−| Molecular Weight | 76.6 kDa |
|---|---|
| Protein Length | The recombinant Human Transferrin protein consists of 690 amino acids and has a predicted molecular mass of 76.6 kDa. The apparent molecular mass of the Human Transferrin protein is approximately 70-100 kDa in SDS-PAGE under reducing conditions. |
| Protein Sequence | Amino acid sequence derived from Human Transferrin protein isoform (P02787, Met 1-Pro 698) with a polyhistidine tag at the C-terminus was expressed. |
| Purity | ≥95 % as determined by SDS-PAGE |
Storage & Handling
−| Storage | Lyophilized Human Transferrin proteinshould be stored desiccated below -20°C. Upon reconstitution, the protein should be stored at 4°C between 2-7 days and for future use below -20°C. For long term storage it is recommended to add a carrier protein (0.128% HSA or BSA). Please prevent freeze-thaw cycles. |
|---|---|
| Form/Appearance | Lyophilized from sterile PBS, pH 7.4. |
| Expiration Date | 6 months from date of receipt. |
| Hazard Information | The product listed herein is for research use only and is not intended for use in human or clinical diagnosis. Suggested applications of our products are not recommendations to use our products in violation of any patent or as a license. We cannot be responsible for patent infringements or other violations that may occur with the use of this product. |
| Disclaimer | For research use only |
Alternative Names
−PRO2086 Protein; TFQTL1 Protein; HEL-S-71p Protein, Human; PRO1557 Protein; Transferrin Protein,Siderophilin, partially saturated
Similar Products
−Human Soluble Transferrin Receptor 1 (sTfR1) ELISA Kit [orb1807196]
Human
6.25-400ng/mL
3.75 ng/mL
48 T, 96 T

Quality Guarantee
Explore bioreagents carefree to elevate your research. All our products are rigorously tested for performance. If a product does not perform as described on its datasheet, our scientific support team will provide expert troubleshooting, a prompt replacement, or a refund. For full details, please see our Terms & Conditions and Buying Guide. Contact us at support@biorbyt.com.
Documents Download
Datasheet
Product Information
Request a Document
Protocol Information
Human Transferrin protein (orb3148125)
Based on 0 reviews
Participating in our Biorbyt product reviews program enables you to support fellow scientists by sharing your firsthand experience with our products.
Login to Submit a Review